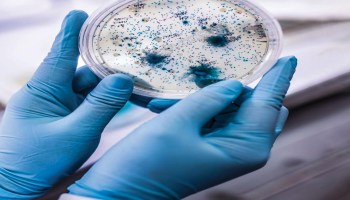
Khobaib 

مرض غامض في #اثيوبيا
 تصفر عيونهم وينزفون قبل وفاتهم

قالت صحيفة الديلي ميل البريطانية الأ...

سلاسل التغريدات
ليتنى وجدت من ينصحني هذه النصيحة فى مقتبل عمري، قال الإمام بن الجوزى : ( إكتم عن الناس ذهبك وذهابك ومذهبك)، فأما ذهبك : فمالك وحالك وكل نعمة تنعم بها ، فلو معك مال قد تكون عرضة لل...
هذه ٥٠ قاعدة وتسمى قواعد المناقشة وتدرس في المدارس الألمانية : خمسون قاعدة عن فن قبول الاختلاف والتعايش بين البشر لا بد من معرفة التالي عندما نتناقش 1- أنا لستُ أنت 2- ليس شرط...
إستراحة مع الشعر النبطي الهمباتي الاغبش: وين لي دوكة يا صاحبي الزُرُق تعالا هاج قبليها شرط لي الدماس وإتلالا طلق نساما كَبَريت من قوارير نالا ما تقول ليا خرطوم ام سموم وعلالا (1...

السودانيين كسولين وجهلة وما عندهم تأريخ ! معلومات قد تهمك ماذا كان يسمى السودان قبل هذا الإسم أ/ تاسيتي وتعني أرض القوس الألفية الرابعة قبل الميلاد ب/كوش القرن التاسع قبل الميلاد...

من هي الدكتورة حاجة كاشف والدة الدكتور أكرم علي التوم؟ حاجة كاشف بدري لها الرحمة والمغفرة ولدت “حاجة كاشف” بمدينة أمدرمان في حي بيت المال، وتلقت تعليمها الابتدائي والثانوي بأمدرم...

صَهْ يا كنارُ وضعْ يمينكَ في يـدي ودعِ المزاحَ لذي الطلاقـةِ والددِ صه غيرَ مأمـورٍ وهـاتِ هـواتناً دِيَماً تهشّ علـى أَصِـيد الأغـيد فإذا صغـرتَ فكـنْ وضـيئاً نَيّراً مثلَ اليراعـ...

وفاة مريض بـ”كورونا” تم تشخيصه “ربو شعبي” تتسبب في كارثة بالمناقل الخرطوم: محمد الطاهر تسببت وفاة مريض مصاب بفيروس “كورونا” بعد أن شُخص بحالة ربو شعبي، وخالط عددا من الكوادر الطب...
بمساحة ثلاثمائة و64 ألف متر مربع و1760 عمود مرصعة بالزبرجد واللازوت والذهب وبقبة قطرها 209 أمتار وعرض حائط 60 مترآ العثور على أضخم معبد لسيدنا سليمان عليه السلام في شمال السودان وب...
Khobaib مرض غامض في #اثيوبيا تصفر عيونهم وينزفون قبل وفاتهم قالت صحيفة الديلي ميل البريطانية الأحد، إن الإثيوبيين ينزفون من أنوفهم وأفواههم قبل أن يسقطوا ميتين جراء الإصابة بمر...

#منقول عايزه أحذّر البنات من الخلية البتسرق قروشهم بإنهم يعملو ليهم عملية إعادة غشاء البكارة. اول حاجة شفت اعلان في الفيس دخلت للبت خاص و ادتني تفاصيل العملية كاملة و بعد اتأكدت ان...
خطبة بروفيسور #عبدالله_الطيب خالية من حرف الراء .. خطبه خاليه من حرف الراء للبروفيسور السوداني عبدالله الطيب ﺍﻟﺤﻤﺪ ﻟﻠﻪ ﺍﻟﻘﺪﻳﻢ ﺑﻼ ﺑﺪﺍﻳﺔ , ﻭﺍﻟﺒﺎﻗﻲ ﺑﻼ ﻧﻬﺎﻳﺔ , ﺍﻟﺬﻱ ﻋﻼ ﻓﻲ ﺩﻧﻮﻩ , ﻭﺩﻧ...
ملاحظ الأيام دي كل واحد إملأ ما عندو وسجود السهو ما بيعرف يجيبو ، وعايز ينظر في الدين ومركب مكنة مجتهد ، يا أمة لا إله إلا الله محمد رسول الله ، الإجتهاد عنده شروط ومن ضمن شروط الم...

